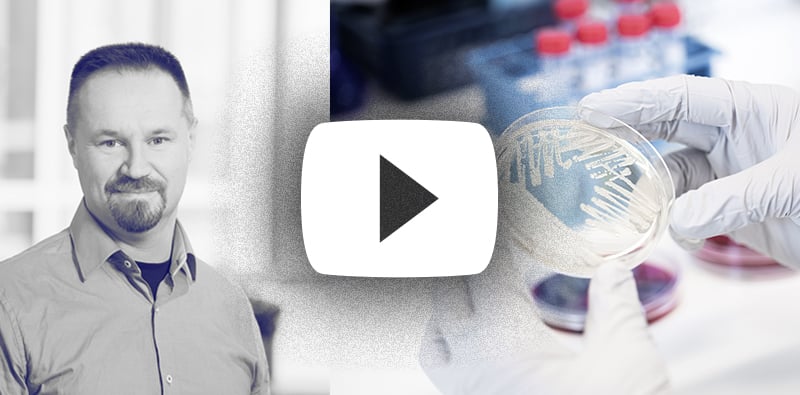

See the webinar recording
Tailormade microbiological analyses — when your strain won’t dance according to standards
Speaker:
Jouni Heikkinen, PhD, Key Account Manager, Biosafe
Jouni Heikkinen, PhD, Key Account Manager, Biosafe
In the webinar, we will go over these topics and scenarios:
- What if the strain doesn't grow in standard conditions in antimicrobial susceptibility tests?
- Analysis of probiotic strains from in vivo coccidiostat compatibility samples.
- Presence or absence of antimicrobial production in special cases.